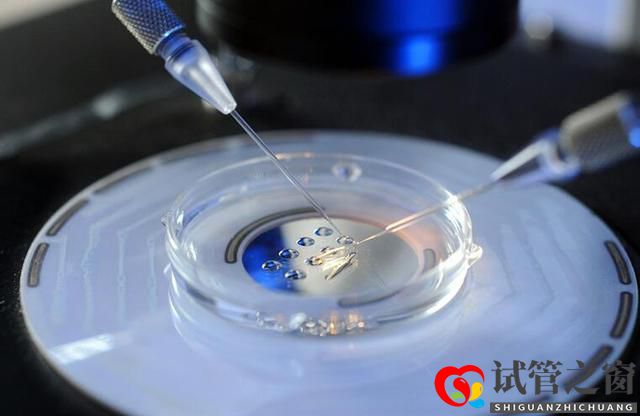
关于试管婴儿的几大误区,看看你中了几条(图1) 关于试管婴儿的几大误区,看看你中了几条(图1)

提到试管婴儿,很多人可能会嗤之以鼻,但是随着社会压力的增大和婚育年龄的推迟,许多家庭正在饱受不孕不育的痛苦,试管婴儿也渐渐为多数人接受。不过仍然有很多人对试管婴儿存在一些认知误区,现在小编就为大家罗列几条,看看你有没有中……
1、试管婴儿不是亲生的
一般情况下都是亲生的。
试管婴儿是体外受精-胚胎移植技术的俗称,是指分别将卵子与精子取出后,置于培养皿内使其受精,再将受精卵移植回母体子宫内发育成胎儿直至分娩出来。胎儿所以遗传物质仍来源于母亲父亲,所以试管婴儿肯定是父母亲生的。
当然不排除有些试管婴儿是用共精做的,比如男性患有无精症,又需要做试管婴儿,所以就用共精的试管婴儿。

2、试管婴儿是在试管中长大的
无稽之谈!!!
试管婴儿”并不是真正在试管里长大的婴儿,而是从卵巢内取出几个卵子,在实验室里让她们与男方的精子结合,形成胚胎,然后转移胚胎到子宫内,在妈妈的子宫内着床,妊娠。
所以试管婴儿之“试管”是在发育成受精卵之前所处的环境,之后移植进入母体,成长过程和普通胎儿无异。
3、做试管婴儿违法
首先,在中国做试管婴儿是合法的。
其次,中国对于做试管婴儿的条件有着严格的限制,是需要能够提供结婚证、身份证、准生证以及提供不孕不育的医学证明,这样的情况才是可以合法作试管婴儿的。
法律不允许的选择胚胎性别、辅助生殖(如代孕)等是不被允许的。所以有很多不符合条件的人士选择到其他国家操作试管婴儿助孕。
4、做试管的都是不能自然受孕的
能正常受孕却选择做试管婴儿有两种人:
一种是能自然生育却患有家族遗传病的人;另一种就是能自然生育但是有性别需求的人。这种需求目前在中国而言是不合法的,因为违背伦理和人道主义,所以很多人会选择到国外做,比较知名有泰国和美国等。
5、试管婴儿不如自然受孕的健康
试管婴儿技术从1978年世界上第一例试管婴儿诞生到国内1988年第一例试管婴儿技术产生,目前为止已经经历了30-40年的历史,从大数据来看,试管婴儿的孩子和正常人的孩子是没有差别的。
恰恰相反,现在的第三代试管婴儿技术,能够对已经发现了一些基因问题、染色体水平的问题进行规避,所以试管婴儿技术的科学性尽量的避免了试管婴儿带来的一些副作用。从目前来看,试管婴儿技术还是比较可信的,尤其是由于精子简单的异常,没有发现遗传性疾病的人,是能够达到完成有自己后代的目的。
不过话说回来,试管婴儿毕竟是有违自然规律的,弊端没出现不代表没有。很多家庭做试管也是无奈之举,试管技术在某种程度来说解决了一些家庭的“失独”问题。况且,胎儿出现问题必定是多方面的,比如其父母的身体状况、遗传因素,再者就是医疗技术。
科学是中立的,关键看人类怎么利用。随着医疗技术的进步和人们观念的转变,社会对于试管婴儿会更加包容和理解,同时完善相关法规法律。






